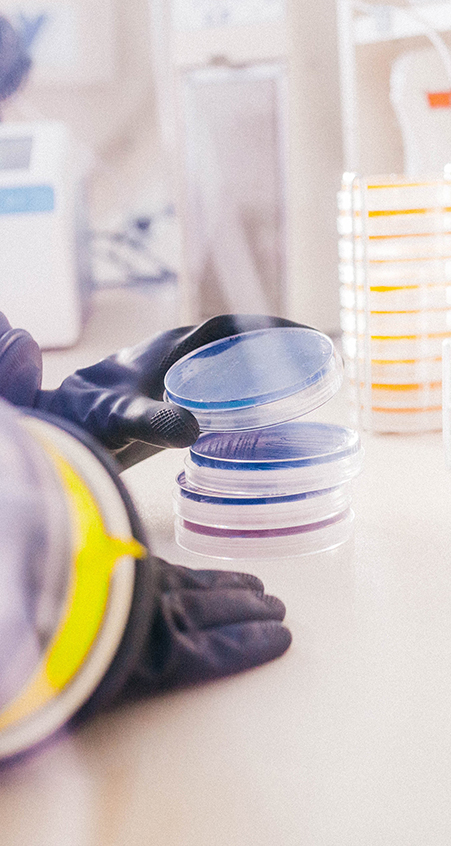
microviable-05 microviable-05
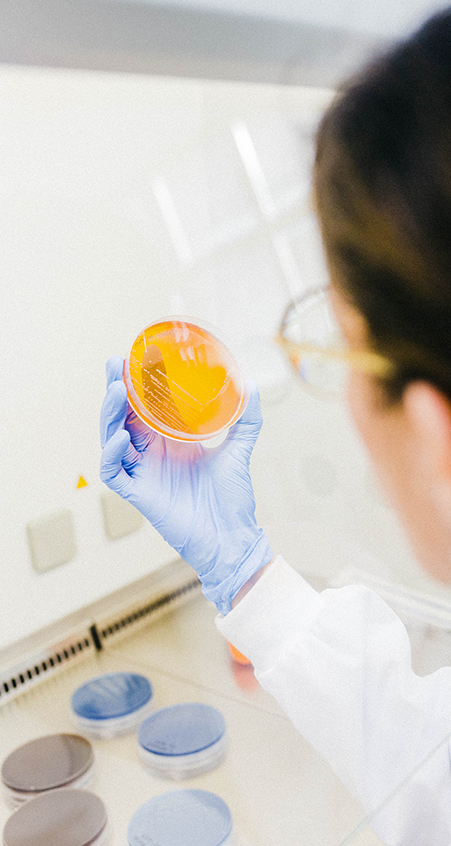
microviable-06 microviable-06

La microbiota humana es el conjunto de microorganismos (bacterias, virus, hongos, etc.) que habitan en diferentes partes de nuestro cuerpo. Sobre ella, a día de hoy se saben varias cosas: la recibimos de nuestra madre y el entorno cuando nacemos, va evolucionando a lo largo de nuestra vida y se ve afectada por varios factores que, además, son los mismos que afectan a nuestro estado de salud, como la dieta, ejercicio, alcohol, estrés, etc.
Microviable Therapeutics ha conseguido el desarrollo de un producto único con mucho potencial en distintas aplicaciones clínicas como un nuevo medicamento biológico, que avanza hacia la fase de ensayo clínico en cáncer colorrectal. ¡Y ahí es donde entras tú!
Para poder ayudar a los pacientes y continuar con validación, necesitamos donantes que participen en este ensayo. De esta forma, podrás ayudar a salvar vidas, contribuyendo a mejorar la eficacia de los tratamientos oncológicos actuales.
¿Qué tienes que hacer para participar?
El proceso para participar es muy sencillo:
¡Y pronto nos pondremos en contacto contigo!
Preguntas Frecuentes:
¿Quiénes Somos?
¿Cómo puedes donar?
Y tu donación, ¿dónde va?
¿Por qué es importante donar?
¿Por qué donar?
El viaje del donante
El proceso es muy sencillo: ¡dona tus heces!
1. Primeras impresiones.
Contacta con nosotros, rellenando un sencillo formulario.
2. Toma de contacto.
Nos pondremos en contacto contigo, con un cuestionario más completo.
3. Nos conocemos.
Si eres apto para realizar el ensayo, enviamos los datos de una clínica, para que puedas hacerte un chequeo completo.
4. Compartimos el marrón.
Te enviamos un kit a domicilio para que puedas recoger tus heces y que nos la envíes de vuelta.